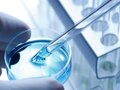
Thu hoạch - Thực hành: Quan sát và lắp mô hình ADN

Thu hoạch - Thực hành: Quan sát và lắp mô hình ADN
Cùng tiến thành quan sát và lắp mô hình để hiểu rõ hơn về cấu trúc không gian của ADN
Soạn sinh học 9 bài 20 thực hành quan sát và lắp mô hình ADN giúp bạn ôn tập kiến thức và trả lời tốt các câu hỏi bài tập trang 60 - 61 SGK Sinh học 9
Cùng tiến thành quan sát và lắp mô hình để hiểu rõ hơn về cấu trúc không gian của ADN